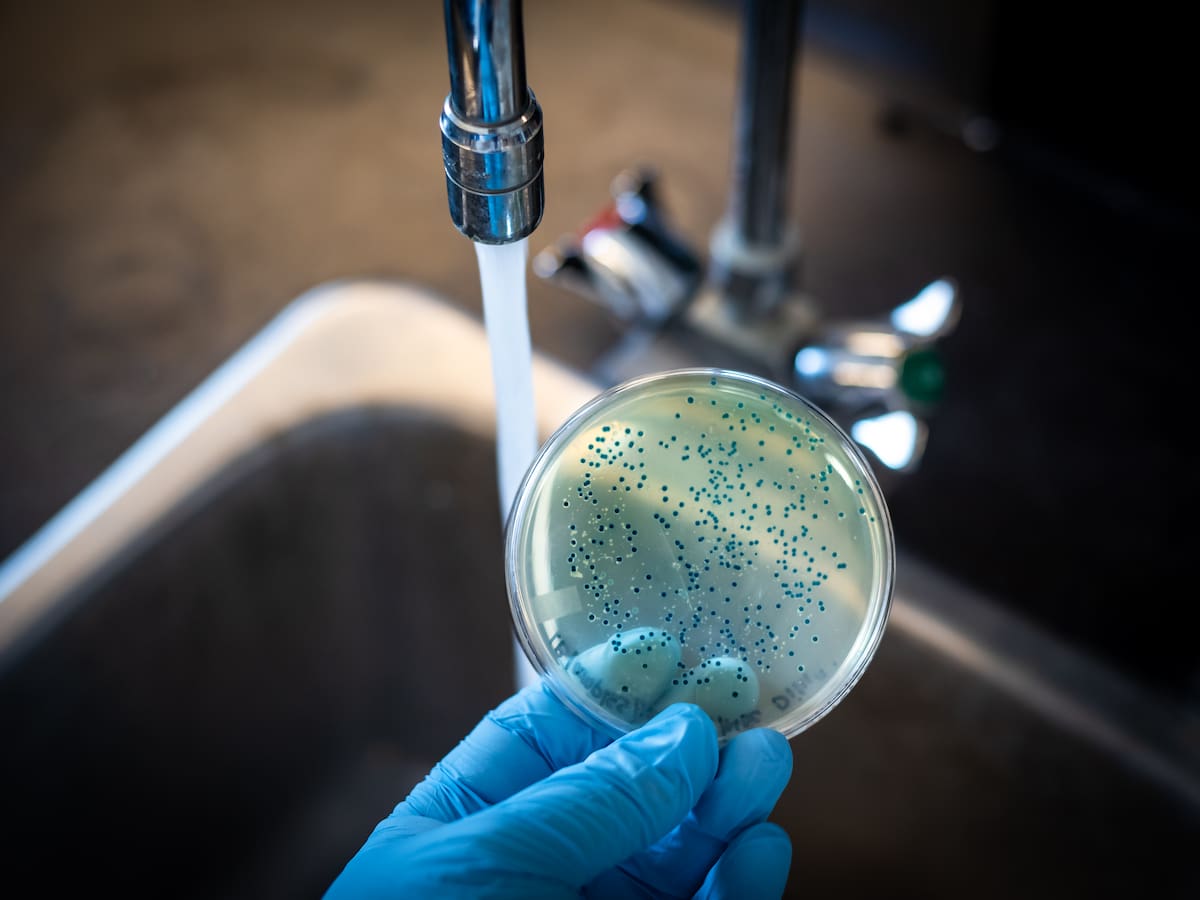

Escuchar
01:38
Sanidad prohibirá fumar en los vehículos de trabajo como furgonetas y campus universitarios
Mónica García avanza en la Cadena SER que además de terrazas y marquesinas tampoco se podrá fumar en campus universitarios o salas de fiestas exteriores
29/05/2025 - 07:18
Mariola Lourido
Madrid